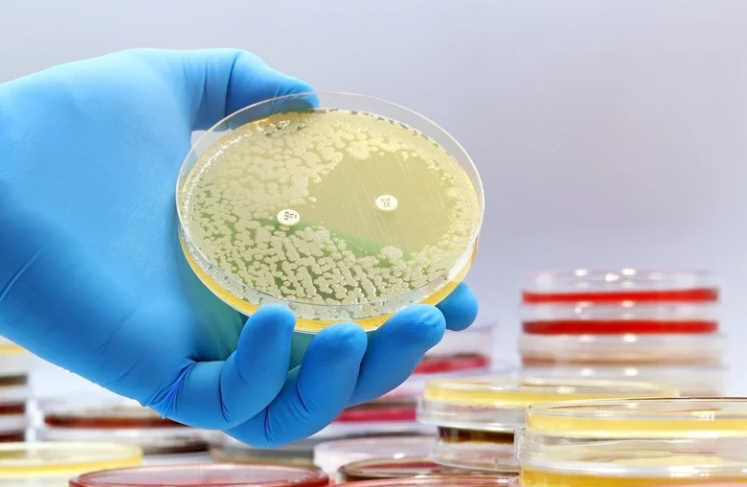

Oh, the markets.
Cool fact from a friend of ours…
The $65 trillion market cap of the US stock market is $25 trillion higher than the end of 2022.
That growth in market cap in less than three years – just the increase – is higher than the total market cap of Japan, all of Europe, and the UK…combined!
Here we go…
Strong Corporate Earnings: S&P 500 Surges, Tech Sector Explodes

S&P 500 companies reported an average 9.2% earnings growth for the quarter. Information Technology led the pack with a blistering 22% profit jump.
Source: FactSet Earnings Insight
Commentary:
Robust corporate earnings often translate to higher dividends and improved stock valuations, a boon for retirees who rely on portfolio income. It’s critical to note which sectors drive growth—today, information technology is the clear leader, but it also carries volatility. For investors near or in retirement, the lesson is balance: overweighting any one growth sector can increase risk, but sensitivity to market leadership can provide opportunities for above-average returns. Leveraging these insights within a diversified asset allocation protects principal, maintains income, and adjusts with changing market tides—essential for a sustainable, enjoyable retirement.
Financial Planning AI Readiness

A Financial Planning AI Readiness Survey of 250 firms found most advisors now leverage AI for tasks such as legal document summaries and portfolio analysis, but many view AI-driven investment decisions as an organizational risk.
Source: Financial Planning – AI Readiness Survey

Commentary:
Technology is changing the advice landscape rapidly. AI can help process vast amounts of information, leading to efficiency and sometimes improved investment insight. However, for high-net-worth individuals with complex needs—multiple income streams, trusts, charitable goals—AI is only as good as the human judgment applying it. The best results come from marrying advanced tools with deep experience, nuanced understanding, and personal relationships. High-caliber planning is rarely “plug and play”; it’s purpose-built for you.
Antibiotic Resistance Risk
WHO’s latest report analyzed 23 million infections in 100+ countries. Shockingly, 1 in 6 no longer respond to standard antibiotics.
Source: WHO Global Antibiotic Resistance Surveillance Report (2025)
Commentary:
Medical innovation and risk management are becoming inseparable from retirement planning. The possibility of rising healthcare costs due to new health threats, like antibiotic-resistant infections, means more of your assets may need to be allocated toward protection—via insurance, health savings, and long-term care planning. Wealth creates options, but only if you prepare for unexpected expenses. Stay educated on health trends, review coverage regularly, and be proactive—not just reactive—when it comes to protecting your longevity and lifestyle.
Retirement Pressures: Inheritance Impatience & Preservation

Emerging trends show adult children pressuring parents to unlock inheritance early (“impatience”), while others urge parents not to spend to “preserve” assets for heirs.
Source: Bloomberg – Inheritance Impatience
Commentary:
Family dynamics increasingly intersect with financial independence in retirement. Whether heirs want early access or feel entitled to your nest egg, the stress can manifest emotionally and financially. Balancing your desires with family expectations requires open communication, robust estate planning, legal clarity, and assertiveness. Remember: Your retirement lifestyle should not be compromised by guilt or pressure—setting boundaries protects both your well-being and your legacy. Make decisions that honor your needs and values, not just those of the next generation.
Investor Sentiment—Charting the Sidelines
Surveys and behavioral finance research show many investors remain on the sidelines, waiting for a “perfect entry.”

Source: CNN Fear & Greed Index
Commentary:
Emotional investing—hopping in and out of markets due to “fear” or “greed”—often leads to suboptimal results. For retirees, consistency is key: stick to a disciplined, goals-based investment plan, rebalance as needed, and let market cycles work for you. Waiting for a “perfect moment” frequently results in missed returns, and sideline anxiety can undermine long-term prosperity. Harness behavioral coaching and evidence-based planning for peace of mind and performance.
Gambling Recovery: Macau & Singapore Boom

Marina Bay Sands (Singapore) is on track for $3 billion in EBITDA this year, with a rich 52% margin, as Asian gaming rebounds.
Source:
Las Vegas Sands Q2 Revenue Report
Commentary:
Industries like gaming highlight global consumer confidence—and opportunities for investors seeking portfolio diversity. However, gaming stocks often swing wildly with regulatory, travel, and economic news. For retirees, it’s wise to treat such investments as satellites, not core holdings—more for growth than for reliable income. Enjoy sector allocation if it fits your risk profile, but never gamble with what you can’t afford to lose.
Amazon’s Robot Revolution = Big Cost Savings

Amazon is cutting 14,000 jobs and expects 40 robot-equipped fulfillment centers by late 2026. Morgan Stanley estimates $4 billion in annual cost savings.
Source: CNBC – Amazon Robots
Commentary:
Automation is both an opportunity and a challenge. For investors, increased profit margins mean the potential for higher dividends (and stock prices). For society, automation changes the labor landscape and can affect broader economic growth. Retirees must watch how these trends impact consumer companies, inflation, and economic cycles. Diversify across industries, and be cautious about too much concentration in any one area—even “sure things” can change quickly.
The Rise of “Working in Retirement”

Prudential’s 2025 survey: Over 80% of mass affluent are considering working in retirement.
Source: Prudential – Global Retirement Pulse Survey
Commentary:
Retirement isn’t just about play—it’s about purpose, challenge, and staying engaged. Many retirees are choosing to work for satisfaction, social connection, and supplemental income. This flexibility can significantly enhance well-being and financial security. Consider how you might blend work and leisure, whether full-time, part-time, volunteer, or entrepreneurial. Your financial plan should reflect your evolving preferences, and not lock you into a stereotypical retirement model.
Mind the Gap: Actual Fund Returns vs. Investor Returns

Morningstar’s 2025 report: The average dollar invested in US funds earned 7% annually over the last decade.
Source: Morningstar Mind the Gap Report
Commentary:
While investment returns headline financial news, the reality for most individuals is often much lower: investor behavior—moving in and out of funds—accounts for much of the “gap.” High-net-worth retirees: Focus on process, discipline, and guidance. Automate good behavior through rebalancing, scheduled withdrawals, and objective review. The right advisor helps protect you from costly mistakes, ensuring you capture more of what the market offers.
The Most Leveraged Masses in 15 Years

Household debt and leverage are near multi-year highs, per the Federal Reserve.
Source: Federal Reserve Financial Stability Report
Commentary:
While the broader public may lean heavily on debt, affluent retirees should prioritize low leverage and high liquidity. Elevated leverage across the economy can foreshadow systemic risks and downturns. Maintain your “personal economy” as a safe haven: reduce debt, keep healthy cash reserves, and avoid overextending—even as others chase returns with borrowed money.
Larry Ellison’s Wealth Surges Past Warren Buffett

Larry Ellison (Oracle) gained $150 billion this year, eclipsing Buffett’s entire net worth ($147 billion).
Source: Business Insider – Tech Wealth
Commentary:
The hyper-acceleration of wealth in tech reminds us: some sectors and visionaries drive massive value creation. However, outsized gains are rarely repeatable or sustainable for most investors. Focus on clear, achievable goals instead of trying to replicate billionaire performance—balance ambition with prudence, and watch “over-concentration risk” in your portfolio.
David Solomon’s Debt Warning: US Nears $40 Trillion

Goldman Sachs' CEO warns: “If we continue on the current course and don’t take the growth level up, there will be a reckoning.” US debt could hit $40 trillion soon.
Source: MSN – Solomon Warns Reckoning
Commentary:
National fiscal challenges impact everyone, especially through interest rates, inflation, and potential changes in tax policy or entitlement programs. Stay vigilant about legislative and economic risk. For retirees, this means: diversify across asset classes, include inflation hedges, and stress-test your plan regularly to anticipate possible government action or market impact.
Final Thoughts: Thriving in Retirement
This week’s economic, investing, and business headlines underscore one central lesson: thriving in retirement is about adaptability, education, and intentional planning. High-net-worth individuals face dynamic opportunities—impressive corporate earnings, AI-accelerated advice, booming sectors—and equally real risks, from health concerns to family pressures, debt cycles, and changing policies.
Here’s what this means for you:
- Balance Growth and Security: Use market insights to calibrate your portfolio for growth without sacrificing income or capital preservation.
- Leverage Technology Wisely: Embrace innovation, but ensure human judgment guides your biggest decisions.
- Anticipate Health and Lifestyle Changes: Build retirement plans that address healthcare uncertainty and personal fulfillment.
- Communicate and Set Boundaries: Proactively address inheritance and family expectations to protect your financial independence and peace of mind.
- Prioritize Process and Discipline: Stay invested according to a logical, adaptive strategy—don’t let emotions or headlines dictate your plan.
- Maintain Liquidity and Flexibility: As economic cycles turn, cash reserves and low leverage are your safety net.
- Stay Purposeful: Consider how work, volunteerism, or new engagements can enhance not just your wealth, but your quality of life.
Retirement isn’t just a finish line—it’s your opportunity to live the richest years of your life. Stay informed, stay flexible, and above all, stay intentional in your decisions. The best outcomes come not just from making money, but from making the most of your time, health, and relationships. If you’d like help tailoring today’s insights into a retirement plan built for lasting enjoyment and security, let’s talk!

